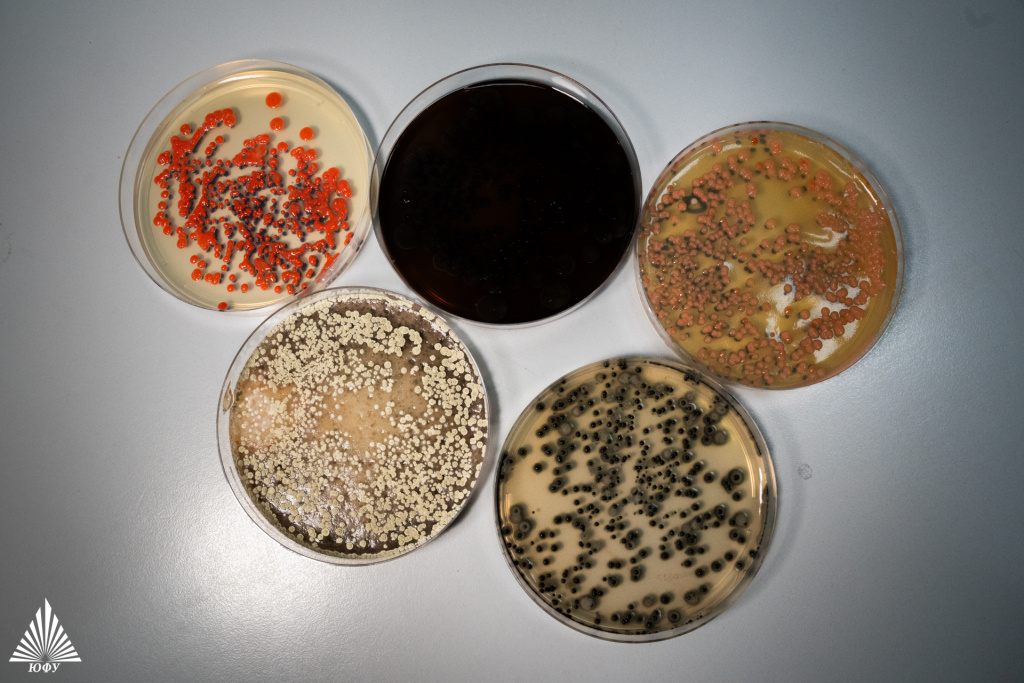
Технологии биоинженерии почв(2)
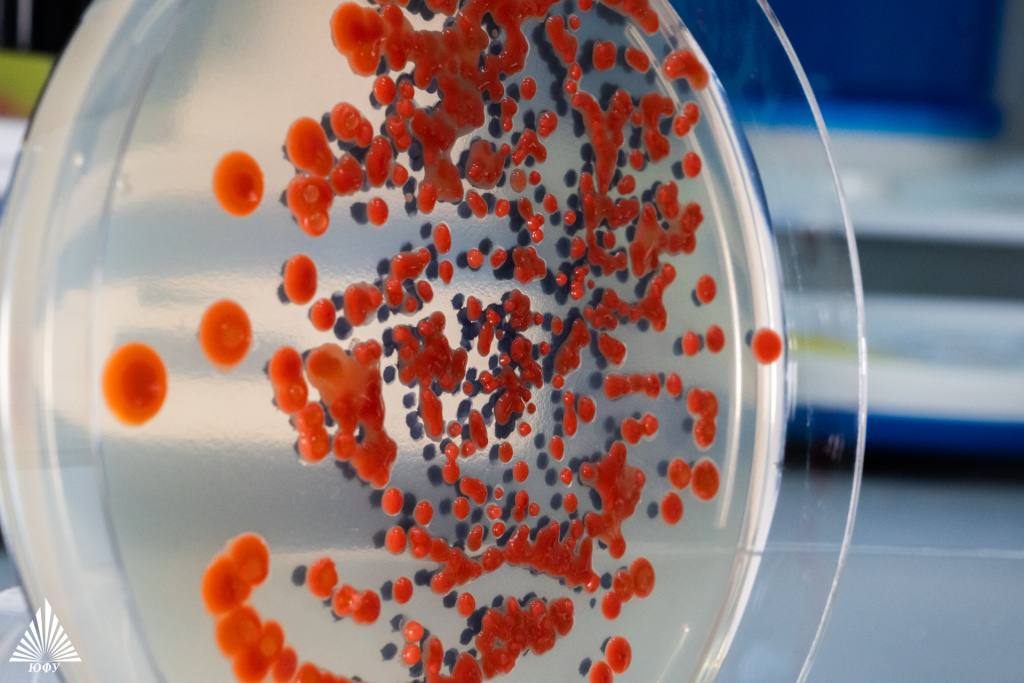
Технологии биоинженерии почв(3)

О проекте
Биоинженерия почв
Проект направлен на создание интегрированной технологической платформы для управления почвами и ризосферой с применением наноматериалов, биоинженерии и искусственного интеллекта. Впервые разработан полный цикл — от диагностики и проектирования микробных консорциумов до формирования и мониторинга искусственных почвенных экосистем.
Проект позволяет восстанавливать деградированные, нарушенные и постпирогенные почвы, создавать почвы с «нуля», перерабатывать органические отходы в углеродсодержащие материалы, снижать антропогенные нагрузки и формировать научную основу для низкоуглеродного земледелия и продовольственной безопасности России. Создание функционального плодородного слоя почвы занимает 18-24 месяца вместо 10-15 лет.
В рамках проекта разработаны биотехнологические решения для ускоренной ремедиации и восстановления здоровья почв, загрязненных тяжелыми металлами и углеводородами; созданы наноматериалы нового поколения — слоистые двойные гидроксиды и нанобиочары, формирующие структурную матрицу искусственных почв; внедрены цифровые и ИИ-технологии для прогнозирования функций микроорганизмов и гиперспектрального анализа параметров урожая; реализованы полевые эксперименты в Ростовской области и республике Калмыкии по созданию искусственных почвенных слоев и восстановлению малопродуктивных земель; создана система интеллектуального мониторинга и моделирования состояния почв с применением дистанционного зондирования и машинного обучения. Все технологические решения основаны на природоподобных принципах, что обеспечивает экологическую совместимость, воспроизводимость и низкий углеродный след.
Созданные решения сочетают экологию, экономику и технологии — превращая отход в ресурс, а почву в управляемую живую систему. Результат: стабильные урожаи ≥80 ц/га с вариацией 12 %; эффективность усвоения питательных веществ растениями на 50 %, что сокращает потери урожая на 40 %; цифровая адаптация под регион за ≤6-8 месяцев.
Удалось создать уникальный устойчивый цикл почвообразования: искусственные почвенные субстраты демонстрируют ферментативную активность и биопродуктивность, сопоставимые с природными черноземами. Таким образом, проект формирует новую парадигму почвенной инженерии, где научные достижения и прикладные решения обеспечивают формирование замкнутой, самообновляемой и управляемой системы «почва — растение — микробиом — цифровая экосистема». Впервые в России и мире применены трансформерные модели машинного обучения для предсказания экологических функций микроорганизмов.

Результаты и продукт
Реализация проекта привела к созданию комплексной технологической платформы, включающей полный цикл разработки — от диагностики и проектирования микробных консорциумов до формирования и мониторинга устойчивых почвенных экосистем.
Ключевые продукты и разработки включают:- Новые биопрепараты и микробные консорциумы на основе фитостимулирующих и уреолитических бактерий, обеспечивающие повышение биопродуктивности культур и биоремедиацию загрязненных почв.
- Наноматериалы нового поколения для создания смарт-удобрений — слоистые двойные гидроксиды (СДГ) с высокой удельной поверхностью, высокой кристалличностью и однофазностью; нанобиочар с высокой удельной поверхностью и объемом пор 0,8–1,2 см3/г, обеспечивающий 3–5-кратное ускорение процессов почвообразования; углеродистые композиты с наночастицами ZnO (наноудобрения), обеспечивающие контролируемое высвобождение микроэлементов в течение 30–45 дней.
- Искусственные почвенные субстраты и органоминеральные матрицы, полученные из песчаных и глинистых компонентов с добавлением нанобиочара, СДГ и неогумуса. Субстраты демонстрируют ферментативную активность на уровне 80–90 % от естественных черноземов.
- Программные и цифровые продукты: нейросетевая модель EcoPredict 4.0 для прогнозирования экологических функций микроорганизмов по геномным и протеомным данным (точность > 85 %); онлайн-сервис (модель SaaS) для дистанционного определения влажности семян подсолнечника по гиперспектральным данным (точность ≥ 95 %); программный комплекс для анализа постпожарных экосистем, интегрирующий аэрофотосъемку и ИИ-модели (точность распознавания повреждений ≈ 89 %).
- Методики и базы данных: экологическое нормирование загрязнителей почв (35 химических поллютантов); индекс здоровья почв, основанный на совокупности биохимических маркеров; база данных генов и метагеномов почвенных микроорганизмов для моделирования микробных взаимодействий.
- Стабильные урожаи зерновых ≥80-100 ц/га в рисковых агроклиматических условиях
- Увеличение урожайности сельскохозяйственных культур на 25 % на деградированных и малопродуктивных почвах
- В области биоремедиации препараты очищают почву от нефтепродуктов на 95 % за один сезон, а их стоимость на 30-40 % ниже зарубежных аналогов
- Экономический эффект включает снижение стоимости анализа на 25-30 % и сокращение сроков разработки новых биопрепаратов с 2-3 лет до 3-6 месяцев
- Созданные наноматериалы и композиты обладают высокими характеристиками: удельная поверхность СДГ — более 80 м²/г, нанобиочара — 250-400 м²/г. Они эффективно поглощают тяжелые металлы (80-95 мг/г)
- Искусственные почвы имеют плотность 1.1-1.3 г/см³, водопрочные агрегаты (более 70 %) и высокую ферментативную активность (свыше 80 % от естественной)
- Цифровые и ИИ-модели показывают высокую точность: EcoPredict 4.0 — более 85 %, гиперспектральный анализ — свыше 95 %, ИИ-анализ постпожарных территорий — около 89 %
Внедрение и коммерциализация
Разработанные технологии и продукты ориентированы на широкий спектр отраслей, связанных с устойчивым сельским хозяйством, экологическим мониторингом и природопользованием:
- Сельское хозяйство и агробизнес — агрохолдинги, фермерские хозяйства, тепличные комплексы, предприятия по производству и применению биопрепаратов и удобрений (ПАО «ФосАгро», ГК «Биона», Агрохолдинг «ЭкоНива», ООО «Марс»)
- Экологическая и биотехнологическая отрасль — предприятия по очистке сточных вод, рекультивации земель и управлению отходами (Эко-СПАС Батайск, Полигон Аксай, Межмуниципальный экологический отходоперерабатывающий комплекс)
- Научно-исследовательские и образовательные организации, внедряющие цифровые технологии и ИИ-инструменты в почвоведении, микробиологии и экологии (НИЦ «Курчатовский институт», Институт почвоведения и агрохимии СО РАН, Harbin Institute of Technology, Сеченовский университет, МФТИ)
- Государственные структуры — Министерство сельского хозяйства РФ, Министерство природных ресурсов и экологии РФ, Росприроднадзор, Россельхознадзор (в рамках экологического нормирования и мониторинга почв)
- Рынки международного сотрудничества — Китай, Монголия, страны Центральной Азии (в частности, фитомелиорация и восстановление деградированных земель)
Проект обладает высоким потенциалом трансфера технологий и масштабирования разработок:
- Ведутся переговоры о промышленном внедрении гидротермальной карбонизации (ГТК) с партнерами из Китая и Монголии (Harbin Institute of Technology, Gobi)
- Технология разработки биопрепаратов на основе консорциумов готова к пилотному внедрению в компании-производители биопрепаратов. Планируется лицензирование программного комплекса и создание сервисной модели для разработки заказных составов микробных консорциумов
- Полевые испытания биопрепаратов и наноматериалов реализованы на площадках АО «Агрохолдинг «Степь» и Донского ГАУ (Ростовская область), что создает основу для лицензирования и сертификации технологии
- Поданы патентные заявки на технологии ремедиации почв, загрязненных углеводородами, и питательные среды для культивирования PGPR-бактерий
- Нейросетевая модель EcoPredict 4.0 готова к коммерциализации по модели Software-as-a-Service (SaaS) для компаний, разрабатывающих микробные биопрепараты
Конкурентные преимущества:
Интеграция технологий полного цикла — от диагностики и биоинженерии до мониторинга и цифрового моделирования, что не имеет аналогов в России:
- — Нанобиочар: удельная поверхность 250-400 м²/г, объем пор 0,8-1,2 см³/г — превосходит Biochar Solutions Inc., Novocarbo на 25-35 %.
— Наноудобрения: контроль высвобождения 85-95 % за 30-45 дней, диапазон температур +5...+45°C, влажность почвы 15-20 % — превосходит ICL Specialty Fertilizers, Vive Crop Protection.
— Микробные консорциумы: разработка за 3-6 месяцев, снижение затрат на R&D в 5-7 раз, эффективность в 3-5 раз выше моноштаммовых препаратов — превосходит Corteva, Koppert, De Sangosse.
— Цифровой двойник почвы: точность ±10 %, устойчивость к потере ~20 % данных превосходит LandScan, IBM Watson Decision Platform, Land InSight.
— Искусственная почва (первая в мире): воспроизведение свойств чернозема за ≤24 месяцев (водопрочность агрегатов > 70 %, плотность 1.1-1.3 г/см³, pH 6.5-7.5), сокращение времени создания от 3 лет и выше до 1 года, прирост урожайности 15-20 %, снижение себестоимости 8-12 %. - Экономическая эффективность: снижение стоимости ремедиации на 30–40 % по сравнению с зарубежными решениями; уменьшение сроков разработки биопрепаратов с 2–3 лет до 3–6 месяцев.
- Экологическая результативность: эффективность очистки почв от нефтепродуктов до 95 %; фиксация углерода в твердой фазе и сокращение выбросов CO₂.
- Технологическая уникальность: впервые применены трансформерные ИИ-модели для микробиологии; разработаны наноматериалы с управляемыми сорбционно-десорбционными свойствами и «умные» системы доставки агрохимикатов.
К 2030 году рынок адаптивных агротехнологий достигнет $67,3 млрд (рост 18,7 % ежегодно). Технология повышает эффективность усвоения питательных веществ на 50 %, сокращает потери урожая на 40 %.
Кейсы
- Полевые испытания в засушливых степях Ростовской области и полупустынях Калмыкии стали первой масштабной проверкой технологии биоинженерии почв. На экспериментальных участках, где десятилетиями царило запустение, команда ЮФУ применила комплексное решение: искусственные почвенные субстраты с нанобиочаром, умные наноудобрения и целенаправленно спроектированные микробные консорциумы. Результат превзошел ожидания: урожайность кормовых трав взлетела на 30–45 % всего за один сезон. Созданные «с нуля» искусственные почвы продемонстрировали ферментативную активность на уровне 80–90 % от эталонных черноземов — почв, формировавшихся тысячелетиями. Фактически ученым удалось запустить ускоренный процесс почвообразования, превратив безжизненный субстрат в функционирующую экосистему за 18–24 месяца вместо 10–15 лет.
- Нейросетевая модель EcoPredict 4.0 не просто предсказала оптимальный состав микробного консорциума для экстремальных условий — этот консорциум прошел испытание космосом. На борту спутника «Бион-2» микроорганизмы выдержали 30-дневный орбитальный полет в жестких условиях радиации и невесомости, сохранив полную жизнеспособность. Это открывает путь не только к восстановлению земель на Земле, но и к созданию систем жизнеобеспечения для внеземного земледелия.
- Лаборатория постпирогенных экосистем ЮФУ впервые применила искусственный интеллект для масштабного анализа территорий, пострадавших от природных пожаров. Разработанные алгоритмы машинного обучения в связке с аэрофотосъемкой и гиперспектральным анализом обеспечили точность распознавания повреждений 89 % — это позволяет в режиме реального времени оценивать состояние лесов и степей, прогнозировать скорость естественного восстановления и принимать обоснованные решения о необходимости вмешательства.

Полный список партнеров
ООО «ОрганикМикс», компания ФОГОД, ООО «Полигон Аксай», АХ «Степь», АХ «Эконива», Harbin Institute of Technology (Китай), ООО «Рыбная ферма «ЭкоДон», Gobi (Монголия), Vaninvena Material (Китай), Институт почвоведения и агрохимии СО РАН, Государственный природный биосферный заповедник Ростовский, Министерство природных ресурсов и экологии Ростовской области, Министерство сельского хозяйства и продовольствия Ростовской области, Ростовский филиал ФГБУ «РосАгрохимслужба», АУ «Калмлес», ПАО Селигдар; ГК «Биона», ООО «Аграрум-Техника», НИЦ «Курчатовский институт», Южный научный центр РАН, МГУ им. М.В. Ломоносова, МФТИ, Институт биохимии и физиологии микроорганизмов имени Г.К. Скрябина РАН, Институт физико-химических и биологических проблем почвоведения РАН, Институт почвоведения и агрохимии СО РАН, Калмыцкий научный центр РАН.
Дополнительная информация
На базе ЮФУ открыты образовательные программы нового поколения в области биоинженерии, наноматериалов, цифрового почвоведения и устойчивого природопользования.
«Мы создаем технологии, которые возвращают почве жизнь, видя в ней не объект, а сложную живую экосистему. Это стратегический ответ глобальным вызовам, где переработка отходов в новые ресурсы рождает не просто решение, а новую философию: из проблемы — решение, из науки — устойчивая индустрия для продовольственной и климатической безопасности».Татьяна Минкина
Руководитель проекта
«В рамках программы «Приоритет 2030» вместе с командой Академии биологии и медицины ЮФУ мы создаем управляемую архитектуру почвы и биоинженерные решения, которые ускоряют формирование гумуса и агрегатов в 5–20 раз, фактически создавая новую почву. Мы говорим не о подкормке, а об управлении почвенной архитектурой — это создает новый класс технологий, который станет такой же отраслью, как семеноводство или биологическая защита. Биоинженерия почв становится новой мировой отраслью, а устранение деградации превращается в инженерную задачу: пустыня, засоление и эрозия больше не приговор. Наше партнерство — первый научно-технологический альянс полного цикла, уникальная связка, которой нет нигде в мире. Россия и ОАЭ могут стать первыми странами, которые создадут экспортную технологию нового поколения — BioEngineered Soil Tech».Илья Марков
Генеральный директор ООО «ОрганикМикс»